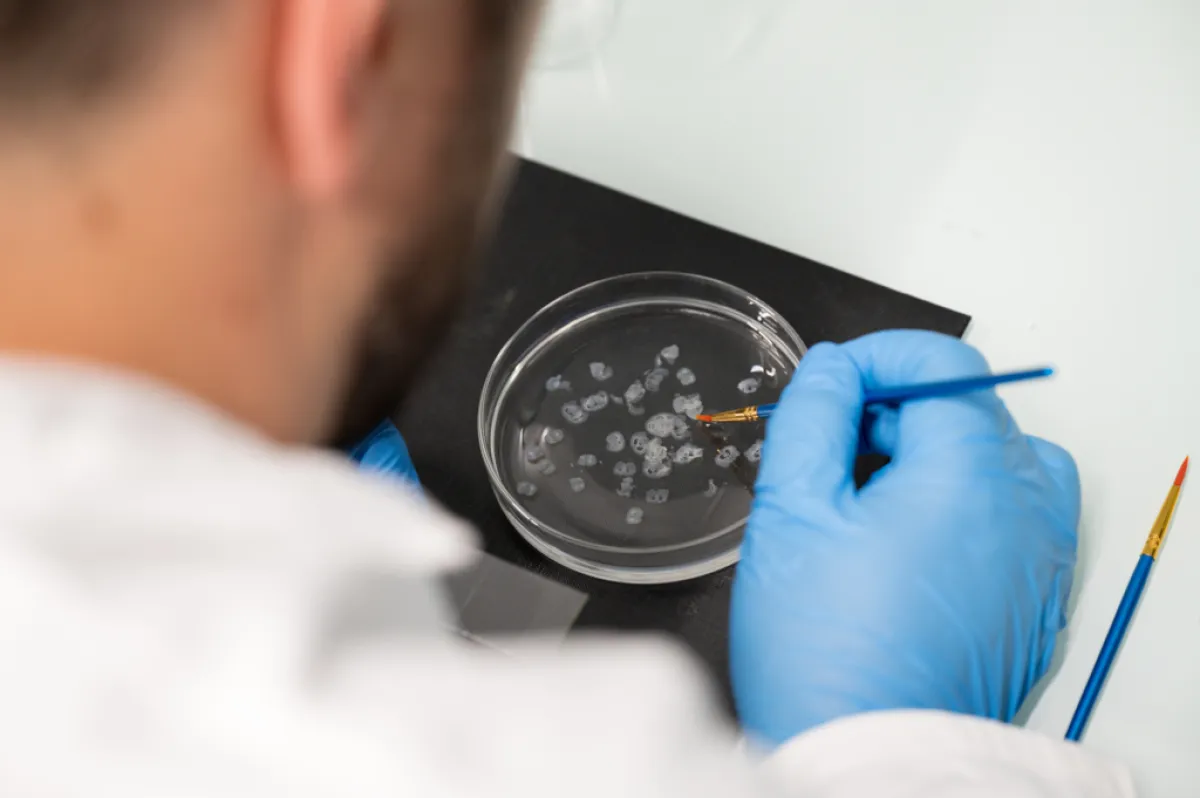

Anna Beyeler Comprendre les voies de l’anxiété pour mieux l’apprivoiser
Anna Beyeler, chargée de recherche Inserm, cheffe de l’équipe « Circuits neuronaux de l’anxiété » au Neurocentre Magendie, Bordeaux
- 2023 • Impulscience

L’anxiété est un phénomène physiologique naturel en réponse à un danger ou à un stress, qui guide nos comportements quotidiens. Cependant, plus de 25 % de la population souffre de troubles anxieux à un moment ou un autre de leur vie. Anna Beyeler a l’intention de déchiffrer l’anatomie et la fonction des réseaux de neurones qui sous-tendent l'anxiété et ses troubles, avec l’ambition de pouvoir les réguler un jour dans l’optique de contrer les effets délétères de ces pathologies.
Nous ne sommes pas égaux face à l’anxiété
Une personne souffre de troubles anxieux lorsqu’elle ressent une anxiété forte et durable qui perturbe son quotidien, sans lien avec un danger ou une menace réelle. De multiples facteurs, y compris des traumatismes physiques et/ou émotionnels de l'enfance, sont liés au risque de développer ces troubles. Cependant, la neurobiologie qui expliquerait la vulnérabilité à développer une telle maladie reste un mystère. Ainsi, les traitements disponibles sont limités et présentent des effets secondaires car leurs mécanismes d'action sont encore incompris. Les traitements le plus souvent utilisés ciblent le système sérotoninergique cérébral, qui produit le neurotransmetteur sérotonine et le distribue dans de nombreuses régions du cerveau. Dans ces régions, la sérotonine régule l’activité des neurones qui s’y trouvent. Il s’agit donc d’un système très puissant et important pour maintenir l’équilibre des fonctions du cerveau, dont le contrôle de l’anxiété.
La sérotonine : un suspect à suivre de près
Des défaillances de la transmission sérotoninergique de plusieurs zones du cerveau ont été observées chez des patients atteints de troubles anxieux. Bien que ces observations cliniques suggèrent un lien entre la sérotonine et l’anxiété, Anna Beyeler veut y apporter des preuves formelles.
Avec son équipe au Neurocentre Magendie, elle se concentre sur la principale source de sérotonine dans le cerveau, le noyau du raphé dorsal, et sur les zones qui reçoivent la sérotonine, dont les circuits limbiques qui contrôlent les émotions. Des technologies de pointe en neurosciences permettront à l’équipe d’Anna Beyeler de décortiquer la contribution de la sérotonine et des circuits limbiques aux troubles de l'anxiété chez la souris.
Comprendre les circuits neuronaux de l’anxiété
Pour mener à bien ce projet soutenu par Impulscience®, l’équipe développera un procédé robuste pour évaluer l’anxiété chez le rongeur. Il s’agit de combiner des mesures physiologiques (rythme cardiaque, température, tremblements) avec l’analyse des comportements de type anxieux des souris. Ces comportements sont quantifiés par de multiples mesures incluant le temps passé dans des endroits protégés, par rapport au temps passé dans des lieux exposés et des mesures fines du comportement détectées à l’aide d’un algorithme d’intelligence artificielle. Ainsi, Anna Beyeler et son équipe identifieront, avec une résolution sans précédent, les signatures d'une anxiété faible ou élevée chez la souris, ce qui permettra de prendre en compte la variabilité et la vulnérabilité de chaque individu.
Ces nouvelles approches permettront de répondre à de nombreuses questions fondamentales :
- Les circuits sérotoninergiques sont-ils les mêmes entre les individus résilients ou vulnérables à l’anxiété ?
- Comment un facteur de risque comme le stress en début de vie, peut-il modifier les circuits cérébraux ?
- Est-il possible de rétablir les niveaux d'anxiété physiologique chez les individus vulnérables en manipulant les circuits sérotoninergiques ?
Ce vaste programme offrira une nouvelle compréhension des facteurs contrôlant les niveaux d’anxiété entre individus, tout en fournissant l’espoir d’appréhender les mécanismes d'action des thérapies ciblant le système sérotoninergique dans le traitement des troubles anxieux.
Anna Beyeler en quelques mots
Anna Beyeler s’intéresse aux circuits de neurones depuis le début de sa carrière scientifique. Pendant son doctorat à l’Université de Bordeaux, elle observe les modifications du système locomoteur du xénope qui surviennent au cours de sa métamorphose. Lors de son premier post-doctorat à Bordeaux, elle mesure l’activité des réseaux de neurones de l’hippocampe, une région du cerveau qui participe à la mémoire et l’orientation dans l’espace.
En 2012, elle déménage à Cambridge (États-Unis) pour son deuxième post-doctorat, afin de décortiquer les réseaux de neurones qui participent à l’attribution d’une valeur (positive ou négative) aux informations sensorielles qui guident notre comportement. En 2017, elle crée son équipe au sein du Neurocentre Magendie, Institut Inserm localisé à Bordeaux, avec laquelle elle cherche à mettre en évidence des altérations des circuits de neurones qui contrôlent l'anxiété chez la souris.

Programme Impulscience
Impulscience attribue chaque année 7 nouveaux soutiens à des chercheuses et chercheurs en sciences de la vie. Concentré sur le milieu de carrière, ce programme a pour objectif de soutenir cette étape cruciale pour le développement des projets de recherche.
Tous les lauréats du prixAppel à candidatures
L'appel à candidatures est ouvert du 7 avril 2026 au 21 mai 2026 pour les candidats ayant répondu aux appels à projet ERC Starting et Consolidator 2025 ; et jusqu'au 22 juin 2026 pour les candidats ayant répondu à l'appel à projet ERC Advanced 2025.